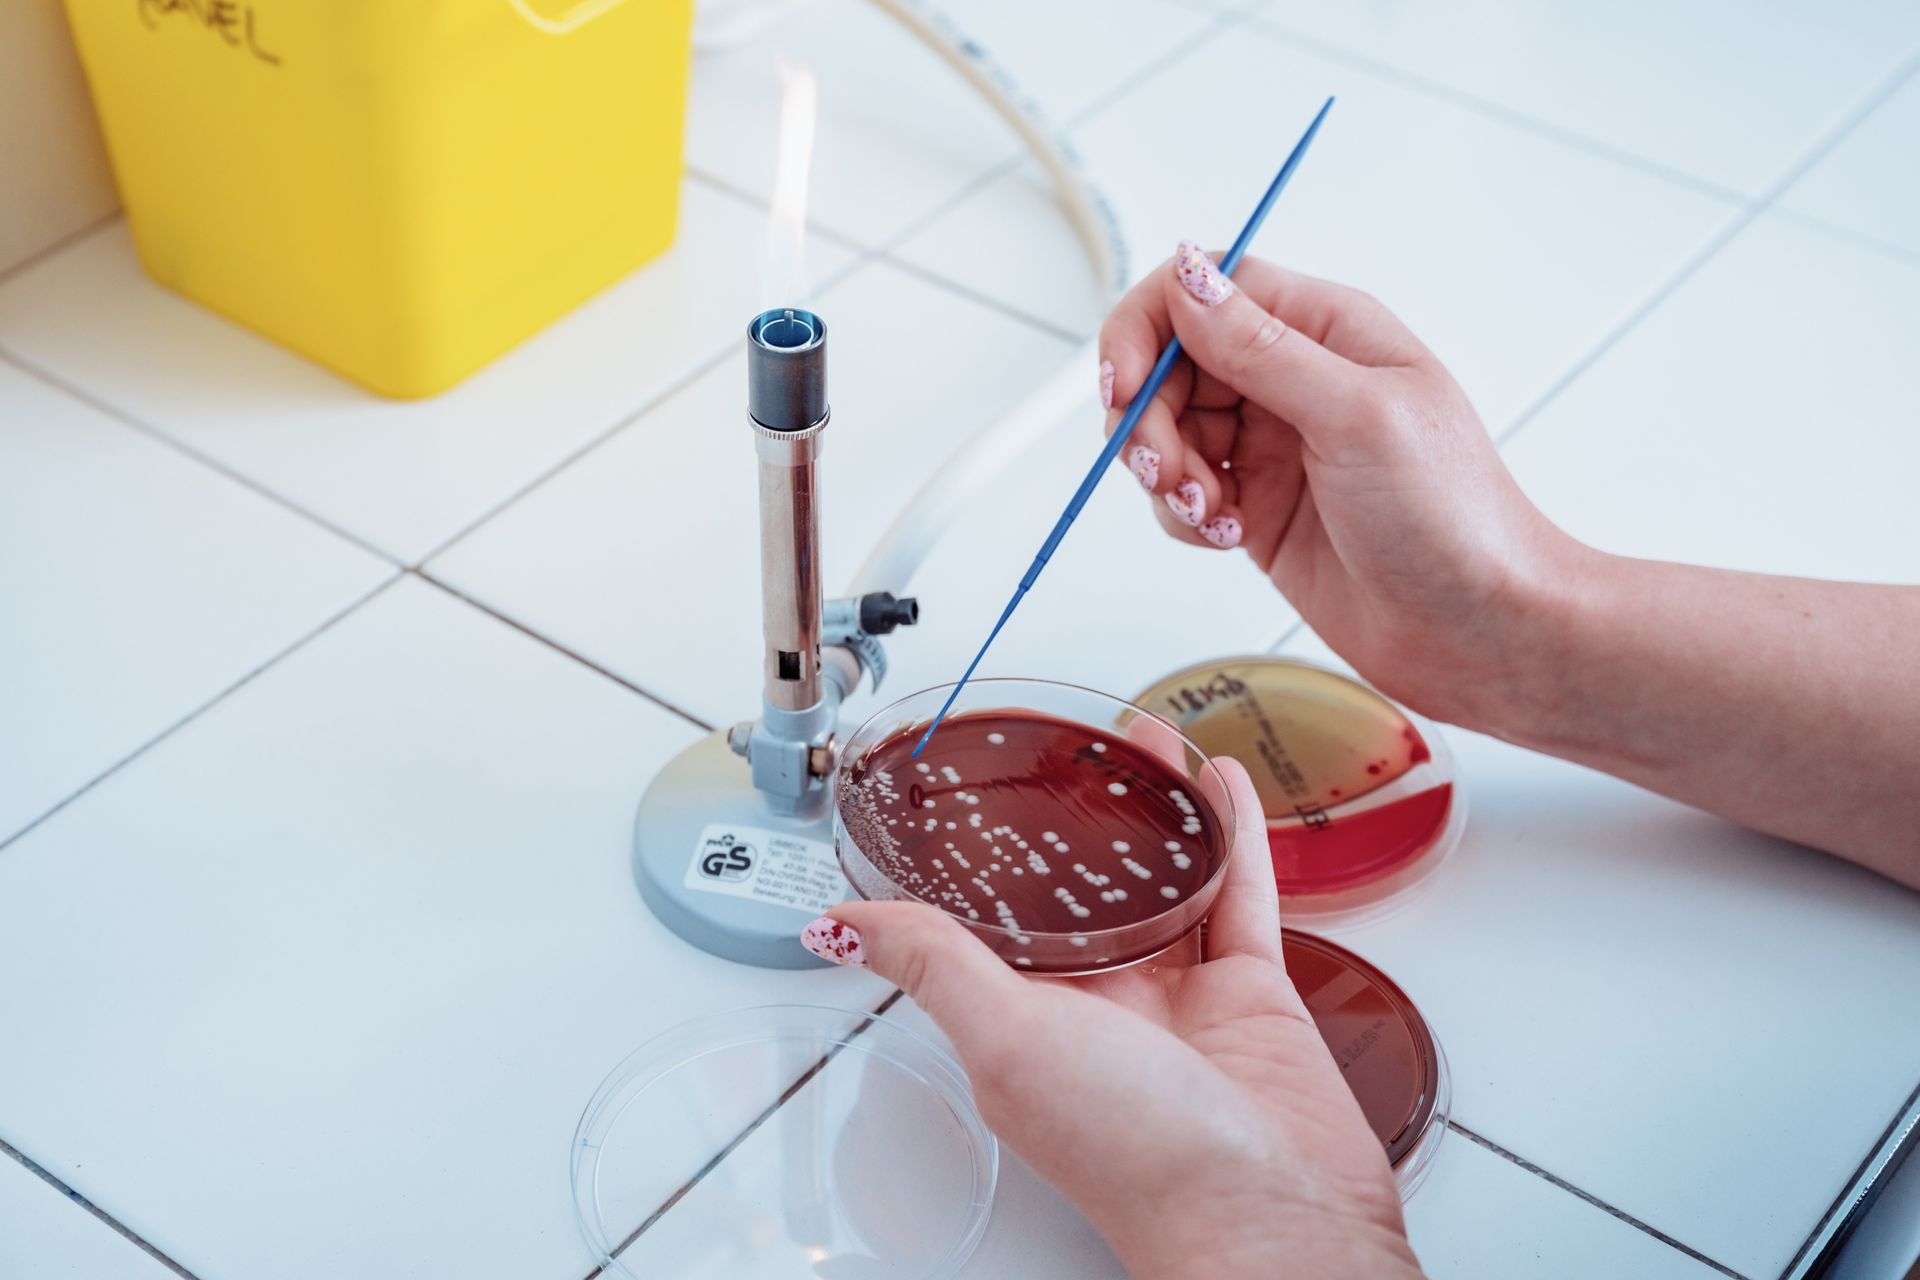
Une personne utilise une anse stérile pour ensemencer une culture bactérienne sur une boîte de Petri près d'un bec Bunsen.

Galerie Logne & boulogne
Notre équipe vétérinaire, ASV en action ainsi que nos structures
Hall d'accueil
hall d'accueil
Clinique vétérinaire de l'Hébergement
ButtonClinique Vétérinaire de Legé
ButtonThérapie laser
Réduit la douleur, améliore la mobilité et d'optimise la qualité de vie de votre animal de compagnie